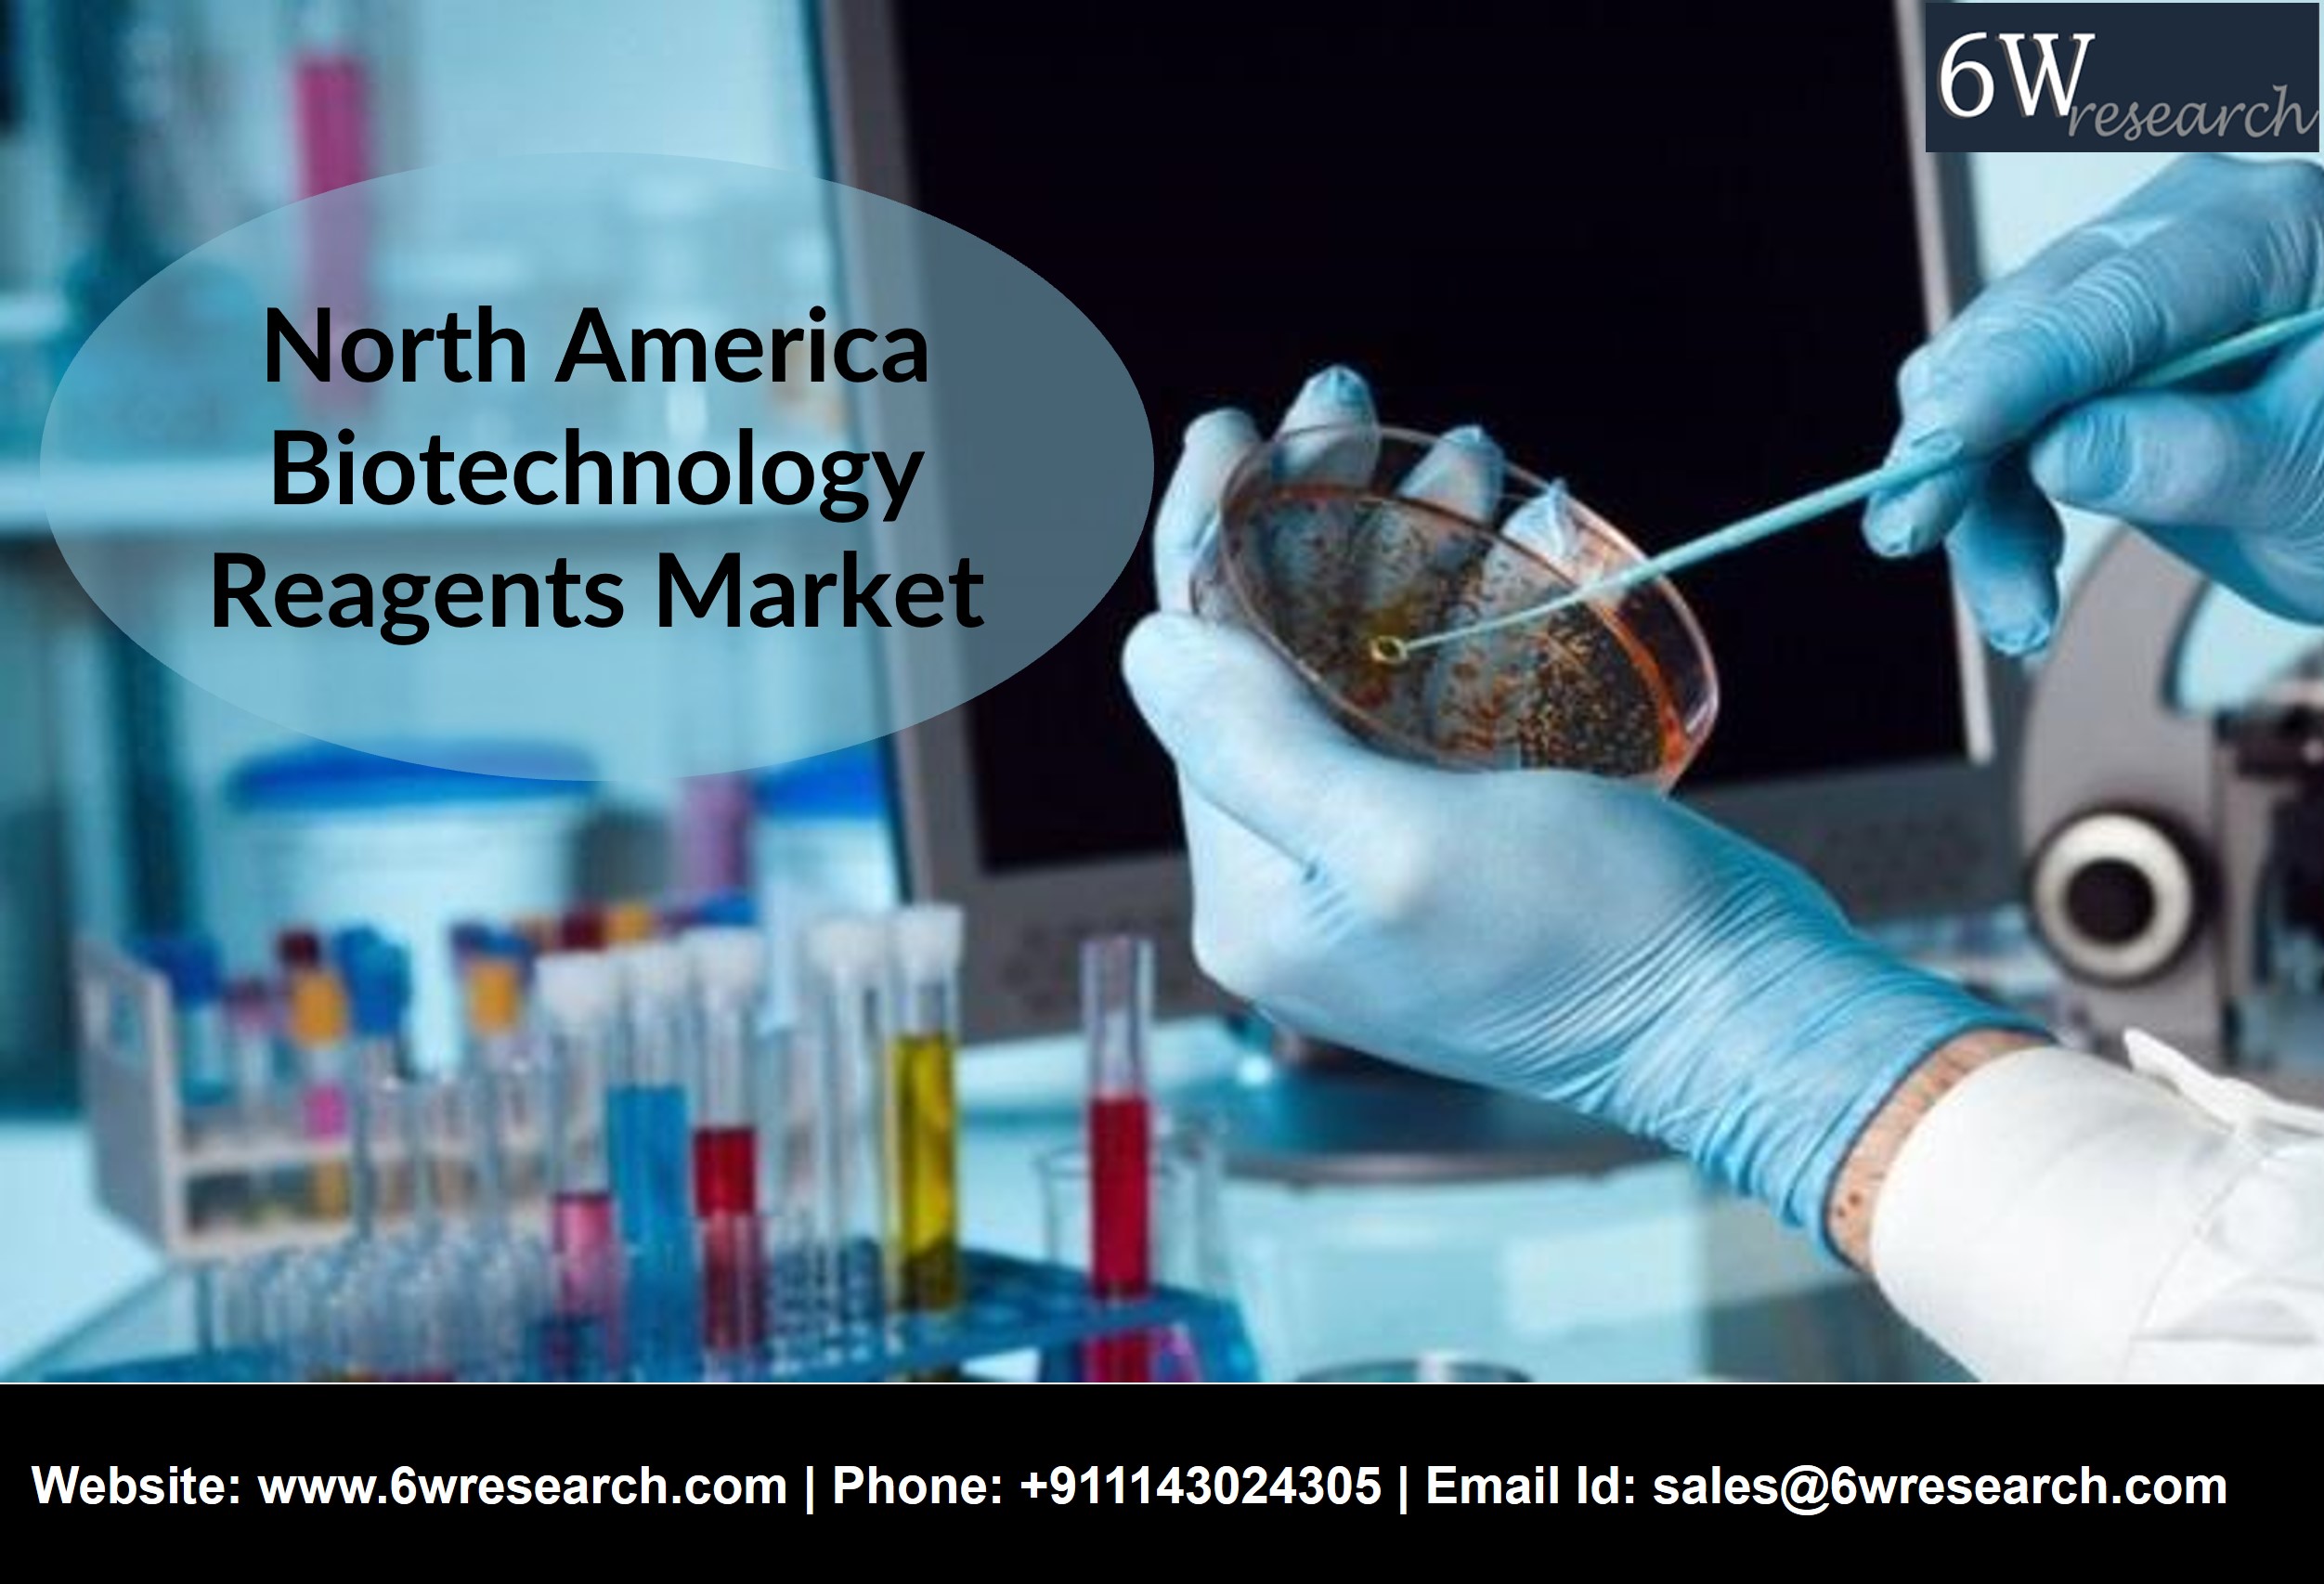

North America Biotechnology Reagents Market (2021-2027) | Trends, Outlook & 6Wresearch
North America Biotechnology Reagents Market Overview
North America Biotechnology Reagents Market is expected to gain growth in the coming years. North America is anticipated the fastest growth of Biotechnology Reagents market in the coming years. USA is the largest producer and exporter of Biotechnology Reagents in the world. The growth of the biotechnology instrumentation market is the primary driver of demand for biotechnology reagents. The Biotechnology Reagents market is expected to grow significantly due to an increase in the number of biotechnology companies around the world and an increase in biotechnology companies research and development spending, which will increase demand. The growth of the biotechnology instrumentation market is the primary driver of demand for biotechnology reagents. Increase in stem cell, gene therapy, DNA molecules, and other biomedical research activities worldwide are the key factors that drive the market growth. Further, the outbreak of COVID-19 pandemic has created a negative impact on the growth of North America Biotechnology market and it is expected to recover over next few years.
According to 6wresearch. the North America Biotechnology Reagents Market is expected to grow during 2021-2027. The major geographies driving the biotechnology reagents market in North America are United States, Canada. The United States and Canada are the major countries that help to drive the market of biotechnology reagents in North America. The United States accounted for the largest share. Due to the growing pharmaceutical industry, surging government funding in life science-based research and rising demand for GMO crops are pushing the market of biotechnology reagents in the United States. Increasing demand for personalized medicine owing to a rise in chronic cases has helped to fuel the North America Biotechnology Reagents market.
The Biotechnology reagents market in North America report thoroughly covers the market by product type, distribution channels, technologies used and countries including USA, Canada among other key countries. The North America Biotechnology reagent market outlook report provides an unbiased and detailed analysis of the on-going North America Biotechnology reagent market trends, opportunities/high growth areas, and market drivers which would help the stakeholders to devise and align their market strategies according to the current and future market dynamics.
Key Highlights of the Report:
- North America Biotechnology Reagents Market Outlook
- North America Biotechnology Reagents Price Trends
- North America Biotechnology Reagents Porter's Five Forces
- North America Biotechnology Reagents Industry Life Cycle
- North America Biotechnology Reagents Market Trend Evolution
- North America Biotechnology Reagents Market Drivers and Challenges
- North America Biotechnology Reagents Market - Key Performance Indicators
- North America Biotechnology Reagents Market - Top Companies Profiles
- North America Biotechnology Reagents Market - Top Companies Market Share
- North America Biotechnology Reagents Market - Import Export Trade Statistics
- North America Biotechnology Reagents Market - Opportunity Assessment By Technology
- North America Biotechnology Reagents Market - Strategic Recommendations
About Us-
6Wresearch is the premier, one-stop market intelligence and advisory center, known for its best-in-class business research and consulting activity. We provide industry research reports and consulting services across different industries and geographies which provide industry players an in-depth coverage and help them in decision-making before investing or entering into a particular geography.
Contact Us: Phone: +911143024305 | Email Id: sales@6wresearch.com